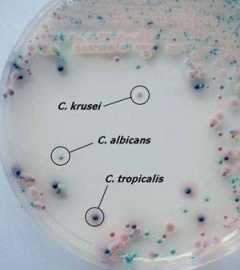
candida2_9_2011032290833_393.jpg

|
• Bioenergetikus természetgyógyászként már több, mint 10 éve kiemelten foglalkozom a CANDIDA GOMBA okozta betegséggel, ill. az alapvetően Candidiázis által kiváltott - fenntartott tünetekkel, tünet együttesekkel. Így, mint bioenergetikus CANDIDA SZAKÉRTŐ természetgyógyász, széleskörű, beigazolódott terápiás módszerrel és tapasztalattal rendelkezem! • Hatékony módszerrel kezelem a REFLUX BETEGSÉGET - nyelőcső betegségeit, és az egyéb eredetű emésztőrendszeri betegségeket, a szív és keringési rendszer elváltozásait, külön figyelmet szentelve ezen kórfolyamatok pszicho-szomatikus voltára. • Bioenergetikus Radiesztétaként vizsgálom az Ön szervezetére ható és környezetében jelenlévő (káros) föld- és mesterséges sugárzásokat, különböző eszközökkel, eljárásokkal kivédem - gyengítem, árnyékolom hatásukat.

A bioenergetikai gyógymód (és a kiegészítő gyógymódok) és az egyénre szabott terápia alapját az a holisztikus szemléletmód képezi, melyben az embert pszicho-szomatikus- és teljes esszenciális egységében vizsgálja és „értelmezi", miközben a szervezet energetikai „üzenete" és szükséglete szerint segíti elő a méregtelítést, és az energetikai harmonizációt a szervcsoportok - szervek -sejtek rezgésszintjének megfelelően.
A BIOENERGETIKAI VIZSGÁLATOT a következő területek vizsgálata képezi a különböző információ tartalmú energetikai rendszereken belül, ill. megjelenési formák szerint:
- FIZIKAI vizsgálat - a fizikai test vizsgálata, mint az anyagi esszencia megjelenési formájának látható, tapintható, szagolható, mérhető jellemzőinek vizsgálata, melyeknek alapját a szervi alaki-funkcionális elváltozások, a megjelenő általános vagy speciális tünetek és az ezekkel járó érzetek, a patogén (betegséget okozó) mikroorganizmusok jelenléte, a különböző sérülések és a fájdalmak, a genetikai - öröklöttségi tényezők, stb. képezik.
- KÉMIAI jellemzők vizsgálata - a fizikális test vizsgálati körébe tartozik ezen belül a mérhető, ill. sejtszintű funkcionális vizsgálat is, úgy, mint pl. a hormonháztartás, tápanyagfelvétel - tápanyagcsere és bomlástermékek kiürítésének és annak jellegének vizsgálata, az egyes tápanyagok hiánya/ túlsúlya, a szervezet jelen pH szintje a különböző területeknek megfelelően, stb..
- ENERGETIKAI vizsgálat, mely a speciálisan mérhető BELSŐ és KÜLSŐ ENERGIA FELVEVŐ - VEZETŐ és TÁROLÓ RENDSZEREK /aura, csakrák, meridián energia csatornák, akupunktúrás pontok/ vizsgálata. Ezen speciális és fizikai megjelenési formában nem látható energetikai rendszerek energia-telítettségük, energiaáramlásuk jellege szerint tájékoztatást nyújtanak a test jelen energetikai - elektromágneses állapotáról, ill. energia felvételi képességéről (a test polarizáltságról), egyben a lelki-érzelmi-szellemi tartalomról, blokkokról is. A speciális energetikai rendszerre hatnak közvetlen módon az információ- és nem a kémiai úton ható gyógymódok, mint pl. a Biorezonancia kezelés, a Homeopátia, a Kristály- és Bach virágterápia, az akupunktúra - akupresszúra és a különböző masszázsok, ill. itt fejtik ki gátló (vagy túltöltő) hatásukat a káros föld- és mesterséges sugárzások.
- GONDOLATVILÁG feltárása, a gondolatok minősége és annak egyénileg jellemző összetett információs tartalma, az ember fizikai értelembe vett Tudata - Öntudatossága, a tudatalatti vizsgálata, mint az emberi (földi energia zóna) lét irányító, és beazonosító „mondhatni szoftver" központja, mely kihatással-befolyással van az ember fizikális-anyag „mint hardver" működésére, és annak egyensúlyi - gátolt, vagy gyógyulási állapotára, ill. a lelki-érzelmi megnyilvánulásaira is.
- ÉRZÉS - ÉRZELEM, mint a LÉLEK fizikai megnyilvánulási - kifejeződési formája, azaz a LÉLEK NYELVE. A jelen lelki állapot - érzelmi állapot vizsgálata, mint tükröződő alkotója a tudati „szoftver" funkciónak. Az ember ÉRZÉS energiája, az érzelem rendelkezik azon kifejezett megvalósító értékű energetikai vonzással, mely kiváltja (létrehozza) a bármilyen jellegű változást, a testi-lelki gyógyulást és az egyéni harmóniát az emberi létérzésben, és fizikai (élet) történéseiben.
A Bioenergetikai - Biorezonancia kezelést, energetikai harmonizálást kiegészítem az Egyén számára leghatékonyabb ősi, és legújabb bioenergetikai gyógymódokkal - hatóanyagokkal, ill. bioenergetikai természetgyógyászati eszközökkel:
Alkalmazott kiegészítő bioenergetikai gyógymódok és tárgykörök:
- Általános Homeopátia terápia (nem vényköteles)
- Bach-virágterápia
- Schüssler-só terápia
- Kristályterápia
- Gyógynövény bioenergetika
- Táplálkozás-kiegészítő gyógyhatású készítmények alkalmazása
- Kolloid oldat- terápiák
- Colon-hydro terápia
- Speciális diéták és életmód

-
Táplálkozás bioenergetika: táplálkozási és tápanyag - élelmezésügyi alapismeretek, emésztés és felszívódás, leggyakoribb ételfertőzések és ételmérgezések leírása, táplálkozás - bioenergetikai ismeretek
-
Vastagbélrendszer és működése, Parazitológia ismeretek és a leggyakoribb parazita fertőzések leírása, bélflóra és a probiotikus terápia
-
Nyelőcső betegségeinek, a refluxbetegség teljes leírása, a reflux általános terápia és diéta
-
A candida gomba és a candidabetegség - candida általános terápia és diéta teljes leírása, candida és a szexuális problémák - hüvelyflóra
-
DNS, RNS és a spirituális DNS bemutatása (a XXI. század és az Új Energia beáramlása, hatása a Föld, az emberiség és az egyéni fejlődésre DNS szinten)
-
Lúgosítás-savasodás → pH és a pH-egyensúly fenntartása a szervezetben, lúgosító és savasító folyamatok, savasító-lúgosító ételek-italok, gyümölcs-zöldséglevek, a szódabikarbóna
-
Fogyókúra-bioenergetikai folyamata és terápia → napi egyszerű diéta-trend, edzésterv, almaecet és tejsavó por
-
Vízterápia és a víz bioenergetikai jelentősége →a víz és szerepe-forgalma a szervezetben, tengervíz, gyógyvizek-és fürdők, víz-programozás, vízkortyolgatási technika
-
Stressz-szorongás-depresszió bioenergetikai folyamatai -és bioenergetikai stressz oldás terápia →a kiegyensúlyozott Önbecsülés megteremtése, és a bioenergetikai Vonzás Törvény
-
Circadian-ritmus, fáziseltolódások, fronthatások, alvás-alvászavarok és az ébrenlét zavarai - alvás bioenergetika, a horkolás és hatásainak
-
Bioenergetikai torna- és mozgásgyakorlatok→ torna- masszázsgyakorlatok testen, ujjon, kézen és arcon (az Öt Tibeti gyakorlat, Mudra- ujjgyakorlatok, energetizáló és fájdalomcsillapító kéz- és arcmasszázsok), légzés - bioenergetika és a Mélylégzés technika
-
Immunrendszer-immunitás → immunrendszer leírása és az immunrendszer támogatása, vér és a vércsoport, a gyulladás és allergia, immunitást erősítő- és tisztító fokhagymakúra
Candida gombáról, micosisról bővebben
Az egyes gombatörzsek - gombafajok szerves részét alkotják apatogén (azaz nem megbetegítő) módon a szervezet különböző területein kialakuló a flórának, a szervezet egyensúlyi állapotának, védekező képességének, a szervezet tápanyaglebontó és kiürítő katabolikus folyamatának. Normális helyzetben a humán apatogén normál gombaállomány és a bakteriális állomány egymással egyensúlyi helyzetben van, mintegy egymás szaporodását és életműködését kontroll alatt tartva. A különböző mikroorganizmusok antagonisztikus viszonyban állnak egymással, így ha az egyik ágens mennyisége csökken (pl. antibiotikum hatására a hasznos bakteriális állomány), akkor a másik ágens túlsúlyba kerül, és már patogén (azaz megbetegítő) módon viselkedhet a szervezettel szemben is (fokozódik a szaporodása és a szervezettől elvont tápanyag mennyisége). A Candida (albicans) gomba patogén elszaporodása a leggyakoribb tényező napjainkban, melynek alap oka az immunrendszer - normál bélflóra legyengülése, a stressz és a túlzott cukor- szénhidrát mennyiség fogyasztása.

A candida gomba fő tápanyagforrása a szénhidrát, csakúgy, mint pl. az agyideg sejteknek, így candidiázis esetén jellemző a csökkent stressz - toleranciaszint, a különböző alvászavarok. A penészgombák csoportjába tartozó candida gombák a légző rendszert támadva gyakran alakítanak ki allergiás és asztmás tüneteket, ill. nem specifikusan beazonosítható módon a felpuffadásos és egyéb emésztőrendszeri tüneteket (gyomor panaszok, refluxbetegség, stb.). A sokszor megbúvó „látens" candidabetegség, a gombatelepek és toxicitása okozta tünetek egyértelmű beazonosítása és kimutatása nem könnyű feladat. Nem specifikus tüneteket - tünet együtteseket hozhatnak létre a szervezetben, sokszor súlyosbítva a már meglévő betegségeket, ill. indikálva azokat. Ugyan nem kell „túlfavorizálni" a candidabetegség tényét (jelenlétét) sem, de nehezen gyógyuló - elhúzódó, vagy halmozottan, ill. jól be nem azonosíthatóan jelentkező tünetek esetén mindenképpen célszerű a célzott candida vizsgálat elvégzése.
Candida albicans gomba elszaporodását elősegítő folyamatok, állapotok:
-
Az immunrendszer gyengesége (betegségek esetén illetve után, veleszületett vagy szerzett immunhiányos állapotokban, operációk és elhúzódó rehabilitációs időszak után, fokozott stressz, ill. fizikai megterhelés során).
-
A hormonális változások során.
-
A szervezet kóros savasodása esetén (acidózis).
-
A higiéniai igénytelenség (hajlatok nem megfelelő tisztítása), vagy folyamatos tisztálkodási akadályoztatás esetén.
-
Összefekvő bőrfelületek (főleg combhajlat) izzadása, szellőzésének hiánya esetén.
-
Penészes környezetben való huzamosabb tartózkodás esetén.
-
A táplálkozási elégtelenség (táplálékhiány, vagy kiegyensúlyozatlan táplálkozás, vitamin és ásványi anyaghiány, savasodás esetén).
-
A Refluxbetegség és a gyomor Helycobacter pylori fertőzéses állapota
-
Kevés bázikus jellegű, azaz lúgos kémhatású táplálék fogyasztása.
-
Elégtelen rostos tartalmú étel fogyasztása.
-
Káros hatású adalékanyagok felhalmozódása a szervezetben.
-
Savas kémhatású ételek túlzott fogyasztása.
-
A kevés folyadék fogyasztása (savasodás, lassult sejtanyagcsere és vérkeringés, méregtelenítési és kiürülési blokk, az /víz/ folyadékhiány önmagában is gyengíti az immunrendszert).
-
A kifejezetten sok cukor, édesség fogyasztás (a gomba alapvető tápanyaga a szénhidrát).
-
Az antibiotikumok többszöri vagy egyszeri (elhúzódó) szedése (illetve után), mivel károsodik a normál bélflóra.
-
A stressz, a depresszió, a hosszantartó feszültség és idegesség (energetikai kimerülés, és energetikai blokkok kialakulása főleg a vastagbélrendszerben).
-
A fogamzásgátlók, hormonkészítmények, szteroidok szedése.
-
A cukorbetegség.
-
A túlzott soványság (bulémia!).
-
A túlsúly.
-
Az amalgámtömések (higany, palládium) és fogprotézis megléte (a nem megfelelő tisztítás és a nehezített rágás miatt).
-
A nehézfém mérgezés
-
Energetikai hiányállapot, melyet akár kiválthat akár egy folyamatosan ható káros radiesztéziai tényező (káros föld -és mesterséges sugárzás), csökkentve ezzel a test energia felvételi képességet (külső - belső energia felvételi tényezők, az emberi test polarizáltsága). 
A szervezet leggyakoribb candida - fertőzöttségi helyei:
-
Candida - bőrfertőzés, mely duzzadásos, kivörösödéses tünetekkel, idővel váladékozó seb kialakulásával járhat. Leggyakrabban az összefekvő bőrfelületeken alakul ki a candida - gyulladásos lob, ahol a bőr meleg és nedves, egyben fénytől elzárt terület. A köröm candida fertőzöttsége esetén a köröm fehér vagy sárgás, idővel elemelkedik az ujjtól.
-
Candida - szájpenész, mely elváltozás esetén jellemző a sárgásfehér, vagy szürkésfehér elszíneződés - lepedék létrejötte a nyelven, szájpadon, a garatban. Vérző felület, seb maradhat a lepedék drasztikus eltávolítása során.
-
Candida - nyelőcső, melynek előfordulása a májzsugorban, ill. a daganatos állapotban a leggyakoribb: A candida telepek gasztroszkópos vizsgálat esetén kimutathatóak, a beteg nyelési panaszokról, hányingerről és reflux-tünetekről panaszkodik.
-
Candida - húgyúti gyulladás (Candida Funguria), mely (elhúzódó) antibiotikus kezelés, ill. helyi eszközös beavatkozás (pl. katéterezés) során szokott kialakulni.
-
Candida - belső szervek gyulladásos folyamata, mely a generalizált, azaz test szerte létrejövő, szisztémás candidabetegség folyamán alakul ki, ebben az esetben a candida gomba, ill. a candida toxin anyaga a vér útján közvetve, szinte minden szervet - szervrendszert megbetegíthet, legyengíthet. Elsődlegesen az emésztőrendszer érintettsége után, legjellemzőbb a légúti szervek és az idegrendszer (agyideg sejtek), ill. a nemi - húgyúti szervek legyengítése és fertőzöttségének a kialakulása. Az immunrendszert is legyengítő kemoterápiás kezelés után gyakran lép fel a máj candida fertőzöttségi állapota, lázzal és változó jellegű hasi fájdalommal. Gyakori a retina candida fertőzöttsége, ekkor pehelyszerű, fehér kis beszűrődések jönnek létre a retinán.
-
Candida - endocarditis, mely átmeneti fertőzésként leggyakrabban a szívbillentyűk beültetése esetén szokott kialakulni, de intravénás fertőzésként is létrejöhet a szív érintettsége (főleg kábítószer élvezők esetében).
-
Candida - hüvelyi fertőzöttsége, mely leggyakrabban kontaktúton létrejövő fertőzés (pl. fertőzött törülköző vagy az uszoda vize), ill. hormonális változás (terhesség, menopauza, fogamzásgátló), cukorbetegség, stressz, antibiotikus kezelés hatására alakulhat ki. Kezeletlenül, ill. elhúzódó hüvelyi candida esetén az egész szeméremtestre átterjedhet a fertőzéses gyulladásos folyamat, égető - csípő - viszkető érzettel és fehér-túrós jellegű váladékozással jár a tünet együttes. Kenet vizsgálat során kimutatott candida fertőzés esetén mind a két félnek részesülnie kell antimikotikus kezelésben a vissza, - ill. keresztfertőződés megakadályozása végett, és lényeges a kontroll kenet vizsgálat! Az eredményes terápia után hüvelyflóra - és bélflóra regeneráló szerek használata prioritást élvez a visszafertőződés megakadályozása és az ellenálló képesség növelése érdekében.


REFLUX BETEGSÉG OKAI ÉS TÜNETEI: Normál anatómiai viszonyok között is kialakul az élettani, ún. Fiziológiás reflux, azaz a gyomornedvtartalom - gyomorsav visszacsorgása a nyelőcsőbe, mely által kis időre megváltozik a nyelőcső pH viszonya. Azonban a nyelőcső perisztaltikus izommozgása gyorsan kiüríti a visszaáramlott tartalmat, egyben a nyál bikarbonát alkotója is segíti a megváltozott vegyi hatás visszaállítását. Kóros reflux, ill. az állandósult reflux betegség esetében a nyelőcső záróizom funkcionalitása már nem megfelelő, nem nyílik és záródik rendeltetésszerűen, így a gyomornedv visszaáramlása és kiürülése folyamatossá válik (tartós regurgitáció). Ez a folyamat idővel elindíthatja a nyelőcső kémiai gyulladásos folyamatát, bővérűséget, majd felmaródást, fekélyes, szűkületi elváltozásokat okozva a nyelőcső falában. A kóros reflux kialakulásában prioritásként szerepel a gyomorsav túltengése, a gyomor gyulladásos- fekélyes folyamata, a fokozott epekiválasztás és a vékonybélfekély, a Helycobacter pylory és a Candida gomba okozta fertőzés, ritkán a nyelőcső visszér kialakulása májcirrózis során. Az elváltozást ezeken kívül kiválthatja még a rekeszizomsérv, kómás - eszméletlen állapotban a hányás, az intubáció (lélegeztető cső levezetése), ritkán a cardiomyotomia (műtéti beavatkozás). Idegi hatásként elsődleges kiváltó és fenntartó okként tartható számon a stressz! A bélflóra egyensúlyi állapotának felbomlása, ill. a rendszertelen (főleg az esti órákra korlátozott) és elégtelen tápanyagtartalmú étkezés (fokozott fűszer és zsír, szénsavas italok használata) egyben a káros föld- és mesterséges sugárzások huzamos hatása az adott területre szintén rizikófaktor. Egyes gyógyszerek, pl. a szteorid- és pyrin tartalmú, vagy hormontartalmú gyógyszerek, ill. a dohányzás és a fokozott alkoholfogyasztás szintén kiválthatják a nyelőcsőfal gyulladásos tüneteit, a reflux tüneteket. A reflux betegség főbb tünetei: - Általában az étkezés után ½-1 órával, ill. az étkezést követő lefekvés után jelentkező szorító - szúró - égető, esetleg csípő jellegű fájdalom a gyomorszáj környékén - Fokozott telítettség érzet, gyakori puffadásos tünetekkel - Sav (és epe) felböfögése, a szájíz savanyú vagy keserű, folyamatos rossz lehelet kíséretében - A nyelv lepedékes, bevont - Nyelési nehézség, súlyosabb esetben nyelési fájdalom - Vérszegénység, vashiány - Gyakori reggeli vagy/és éjszakai köhécselés, esetleg folyamatos rekedtség - Fogzománc fokozott kopása, fogszuvasodás - Következményes alsó- és felső légúti gyulladások, asztmás tünetek - Hiatus hernia (rekeszsérv) kialakulása - Horkolás létrejötte, vagy a már meglévő horkolási állapot súlyosbodása - „Néma" reflux esetén nem tipikusak a tünetek, könnyen csak a légúti panaszokra terelődhet ezért a figyelem (pl. a gyakori „csak" köhécseléses panasz miatt)
A reflux betegség (GERD) csoportosítása a tünetek és elváltozások alapján: A leggyakoribb elváltozás a non-erosív, ún. NERD Reflux betegség, mely még nem jár endoszkóposan (makroszkóposan, azaz jól láthatóan) igazolható nyelőcső felmaródással és szövődményekkel, majd az ún. erosív ERD Reflux betegség, ahol már a nyelőcső hám körülírt hiánya, gyulladása is kimutatható és jól látható, végül az ún. erosív szövődményes ERD Reflux következik (pl. kialakult nyelőcső fekély, Barrett nyelőcső, nyelőcső daganat, stb.) .
Reflux betegség csoportosítása a nyelőcső gyulladásos folyamatának alapján (Savary Miller -féle klasszifikációs csoportosítás):
I, A nyelőcső nyálkahártyán csak foltokban található a gyulladásos elváltozás, nem összefüggő terjedelmű a látható sérülés (lézió) és vérbőség. II, A nyelőcső nyálkahártya sérülés, felmaródás mellett már izzadmányképződés is látható (exszudációs erozió), mely azonban nem terjed ki teljesen, körkörösen a nyelőcső teljes lumenére.
III, A nyelőcső lumenét körkörösen átfogó, összefüggő vérbő gyulladásos folyamat, nyelőcső erozió (felmaródás és körkörös hámhiány), és szöveti elhalás (nekrózis) is jellemzi a fokozatot.
IV, Idült, krónikus nyelőcső lézió (sérülés) és a Reflux betegség megjelent szövödményei képezik a fokozatot.
Reflux betegség csoportosítása a nyelőcső nyálkahártya folytonossága, érintettsége alapján (Los Angeles féle klasszifikációs csoportosítás):
A, A nyelőcső nyálkahártya folytonosságának megszakadása kisebb, mint 5 mm átmérőjű.
B, A nyelőcső nyálkahártya folytonosságának egy, vagy többszöri megszakadása már nagyobb, mint 5mm átmérőjű.
C, A nyelőcső nyálkahártya folytonosságának megszakadása a nyelőcső teljes lumenére (körfogatára) vonatkozóan kevesebb, mint 75%, és kietrjedése több nyelőcső nyálkahártyaredőt érint.
D, A nyelőcső körfogatának 75%-a, vagy nagyobb százalékát képezi a nyelőcső nyálkahártya folytonosságának megszakadása. Bővebben lásd.: reflux.bioenergetikus.hu

Elérhetőség és bejelentkezés:
www.bioenergetikus.hu Budapest: 1074 Budapest, Dohány u. 16-18. félemelet 3. Egészség-sziget Orvos-természetgyógyász rendelő Mócsány Bertalan Bioenergetikus Természetgyógyász Tel.: 06-1/352-0675, 06-1/269-6088 Mobil: 06/20-9446-157 E-mail: termeszetgyogyasz@bioenergetikus.hu Gyöngyös: 3200 Gyöngyös, Seregély u. 32. Aura '95 Bt. Mócsány Bertalan Bioenergetikus Természetgyógyász Tel: 06-37/309-134 Mobil: 06/20-9446-157 E-mail: termeszetgyogyasz@bioenergetikus.hu
|